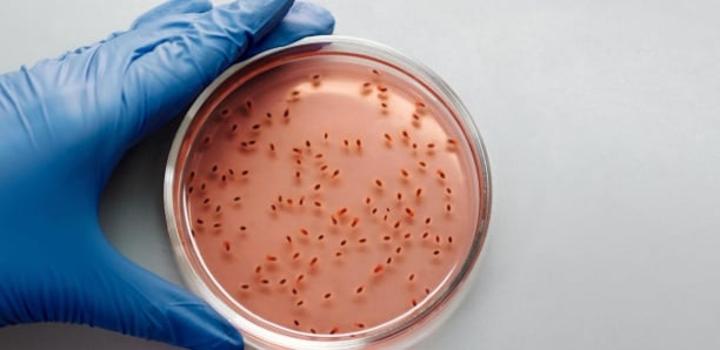

Africa-Press – Senegal. Dans un communiqué publié le 15 mars dernier, l’Institut Pasteur alerte sur l’augmentation des résistances aux antibiotiques de la maladie de la shigellose, qui circule actuellement en France.
La vigilance est de mise. L’Institut Pasteur a alerté, dans un communiqué publié récemment, sur la capacité de résistance aux antibiotiques de la maladie de la shigellose, qui circule actuellement en France.
Cette annonce de l’Institut Pasteur fait référence à une étude sur la bactérie Shigella, faisant partie de la même famille que E.coli ou les salmonelloses, dont est issue la maladie. Les résultats avaient été publiés dans dans la revue Nature Communications le 26 janvier dernier.
Ce sont les chercheurs du Centre national de référence des Escherichia coli, Shigella et Salmonella, rattachés à l’Institut Pasteur qui surveillent cette bactérie sur le plan national depuis de nombreuses années.
UNE MALADIE TRÈS CONTAGIEUSE
D’après les chercheurs, la shigellose est une maladie diarrhéique qui provient initialement d’un manque d’hygiène. En effet, les «shigelles» sont transmises par voie féco-orale. Par exemple, il suffirait que de l’eau ou des aliments soient souillés pour qu’une personne puisse être infectée, en ingérant ces éléments.
«Le plus souvent, la transmission est directe, du malade à son entourage», indique l’étude, ajoutant que du «fait de ses conditions de survenue, la maladie touche essentiellement les enfants vivant dans les régions pauvres et surpeuplées de la planète où les infrastructures sanitaires et l’hygiène individuelle sont insuffisantes».
Elle peut également toucher des militaires en opérations dans ces régions ou encore des touristes et du personnel humanitaire. Et pour cause, toujours selon l’étude, il suffit d’être en contact avec seulement une dizaine de germes (10 à 100 bacilles) pour être contaminé.
Néanmoins cette maladie est aussi présente en France, aux Etats-Unis, au Royaume-Uni ou encore en Australie. D’ailleurs c’est le sérogroupe du S. sonnei qui y circule le plus (sur quatre sérogroupes existants), et qui inquiète particulièrement les scientifiques pour sa résistance aux antibiotiques. De plus, l’Institut observe depuis plusieurs années une hausse significative des cas au sein de la communauté homosexuelle masculine.
DES SYMPTÔMES INQUIÉTANTS
Mais la shigellose peut aussi être mortelle, puisque selon l’Institut Pasteur 200.000 personnes en meurent chaque année, dont 65.000 enfants de moins de cinq ans.
Une fois contaminé, le patient peut brusquement être atteint de douleurs abdominales, accompagnées de «vomissements et l’émission de selles très fréquentes et nombreuses, glairo-sanglantes et purulentes, voire parfois hémorragiques» est-il écrit dans le communiqué.
En plus d’une fièvre élevée, des complications peuvent aggraver la maladie, notamment une déshydratation, une hypoglycémie qui se transforme en choc septique, une insuffisance rénale, une occlusion intestinale pouvant causer une péritonite ou encore une malnutrition. Ce sont ces causes qui sont les plus dangereuses et pouvant aboutir au décès du patient.
COMMENT SE TRAITER ?
Dans les cas de maladies diarrhéiques, la réhydration est souvent proposée comme traitement, or pour la shigellose, ce n’est pas suffisant. Cela s’explique par le fait que la bactérie envahit la muqueuse du colon et provoque une réaction inflammatoire qui conduit à la destruction des tissus infectés voire à des complications à distance. Les antibiotiques permettent généralement une guérison rapide et sans séquelles.
Mais justement, les antibiotiques les plus souvent prescrits, c’est-à-dire l’ampicilline, tétracycline, sulfaméthoxazole-triméthoprime, chloramphénicol et acide nalidixique ne résistent plus à la souche de S. sonnei et de S. flexneri.
Cela oblige désormais à devoir se tourner vers d’autres antibiotiques, plus rares et plus chers tels que les fluoroquinolones, céphalosporines de 3e génération et azithromycine, qui ont donc peu de chances de circuler dans les pays en ayant le plus besoin.
L’Institut Pasteur considère qu’il est tout à fait possible qu’à l’avenir, de nouvelles épidémies de shigellose avec ces souches hautement résistantes aux antibiotiques éclatent. «D’où l’importance et l’urgence de développer un vaccin. Dans la communauté homosexuelle masculine, une prévention sur cette nouvelle infection sexuellement transmissible est à mettre en place» ont rappelé les chercheurs.
Pour plus d’informations et d’analyses sur la Senegal, suivez Africa-Press